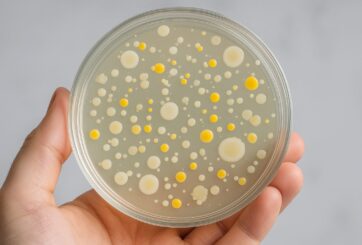
AI Generated Image

Experts update watchlist of species to watch out for in next 10 years Pink salmon, Purple Asian clams, marine invertebrates that form spaghetti-like colonies and a nematode worm that causes extensive deaths of trees are among the new entries in experts’ watchlist of invasive non-native species that could threaten Great Britain in the next 10 years. The latest version of the watchlist, which again includes known problem species such as the yellow-legged (Asian) hornet, raccoon and twoleaf watermilfoil, has been…

Originally from South America, the charismatic tegu made its way to the United States via the pet trade of the 1990s. After wreaking havoc in Florida’s ecosystems, the exotic lizard was classified as an invasive species. But a recent discovery from the Florida Museum of Natural History reveals the reptiles are no strangers to the region — tegus were here millions of years before their modern relatives arrived in pet carriers. Described in a new study in the Journal of…

CAR-T cells cause brain fog After treatment with CAR-T cells — immune cells engineered to attack cancer — patients sometimes tell their doctors they feel like they have “brain fog,” or forgetfulness and difficulty concentrating. A new Stanford Medicine-led study shows that CAR-T cell therapy causes mild cognitive impairments, independent of other cancer treatments, and that this happens via the same cellular mechanism as cognitive impairment from two other causes: chemotherapy and respiratory infections such as flu and COVID-19. The…
Microbial ecosystems have tipping points where even small perturbations are enough to cause a collapse, according to a new study. The authors, from the Helmholtz Institute for Functional Marine Biodiversity at the University of Oldenburg, Germany, describe microbial communities as a network based on cross-feeding, the exchange of metabolic by-products between populations. This network of relationships can collapse abruptly if individual populations are lost, they conclude. This mechanism may explain why microbial diversity is difficult to maintain in the laboratory,…

Researchers from the Keck School of Medicine of USC found that obesity, gestational diabetes and hypertensive disorders of pregnancy were tied to elevated blood pressure in offspring, with effects that grow as children age. Children born to mothers with obesity, gestational diabetes mellitus or a hypertensive disorder of pregnancy have higher systolic and diastolic blood pressure than children born to mothers without these risk factors, according to a new USC study. Among children whose mothers had at least one risk…

A team of researchers from the Department of Diagnostic and Therapeutic Ultrasonography at the Tianjin Medical University Cancer Institute & Hospital, have published a review (DOI: 10.20892/j.issn.2095-3941.2024.0376) in Cancer Biology & Medicine. The paper underscores the potential of AI to decode complex biological data with unprecedented speed and accuracy. By integrating genomics, medical imaging, and pathology at scale, AI is paving the way for data-driven strategies that bring precision medicine from theory into real-world clinical practice. In the realm of…

A new study led by researchers at Sun Yat-sen University has mapped the current and future potential distribution of Physella acuta, an invasive freshwater snail threatening China’s ecosystems, public health, and agriculture. Using advanced climate modeling, the team predicts that while southern China may see shrinking suitable habitats for the snail, northern regions could face increased invasion risk, underscoring the need for targeted monitoring and control strategies. “Physella acuta is a global invader with severe ecological and economic impacts, and China…

In an effort to curb misuse of opioids and prevent overdose deaths, the College of Physicians and Surgeons of British Columbia released a legally enforceable practice standard, Safe Prescribing of Drugs with Potential for Misuse/Diversion, in 2016. This document limited prescribing of opioids for chronic noncancer pain (CNCP) with specific prescribing practices that clinicians were obligated to follow. In research that tested the effects of the 2016 practice standard on prescribing to patients with CNCP, researchers found that its introduction had…

Per- and polyfluoroalkyl substances (PFAS) are ubiquitous, accumulate in the environment and are difficult to break down. They are known as “forever chemicals”. PFAS can compromise the immune system and thus, human health. In their current study, researchers from the Helmholtz Centre for Environmental Research (UFZ) show that high PFAS exposure has a negative effect on the cellular immune response to the SARS-CoV-2 coronavirus. The scientists suspect that people exposed to high levels of PFAS may have a suboptimal immune…

New UBuffalo research indicates that while the residential segregation policy was outlawed decades ago, it still impacts women’s health today BUFFALO, N.Y. – In neighborhoods across America, women face a daunting threat from a federal practice that, although it was outlawed decades ago, continues to negatively impact their health today. That’s according to the findings of new University at Buffalo research that examines how historical redlining — the federal policy from the 1930s where neighborhoods were given mortgage security grades…

The number and diversity of insects is declining worldwide. Some studies suggest that their biomass has almost halved since the 1970s. Among the main reasons for this are habitat loss – for example through agriculture or urbanization – and climate change. These threats have long been known. What is less well-known is how these global change drivers interact and how their effects can become even more severe that way. For example, insects that have been deprived of their natural habitat…

Central Asia, located in the heart of the Eurasian continent, has experienced significant climatic shifts in recent decades, characterized by warming and increased humidity. This trend contrasts sharply with the global pattern of drought-induced tree growth decline, making Central Asia a unique region for studying the impacts of climate change on forest ecosystems. Alpine forests in this region are critical for regional water reserves and ecological stability and are the origins of many inland rivers such as Amu Darya and…

Triboelectric nanogenerators (TENGs) are a transformative class of next-generation devices for energy conversion and self-powered sensing. Selecting appropriate triboelectric and conductive materials is crucial for optimizing TENG performance. In recent years, MXenes, especially Ti3C2 MXene, have become highly promising candidates for both triboelectric and conductive materials in TENGs. Although many studies (including research and review articles) have focused on TENG construction and performance, there is a significant gap in the literature: a comprehensive summary of MXene applications from a materials…

New research reveals that shifts in plant life played a key role in speeding up major climate changes during the late Miocene, a period spanning 11.6 to 5.3 million years ago. During this time, Earth’s climate shifted from the warm conditions of the middle Miocene to conditions closer to what we experience today, turning forests into grasslands and forcing animals like horses and elephants to evolve tougher teeth for eating gritty plants. At the same time, predators like big cats…

In pancreatic ductal adenocarcinoma (PDA), the abnormal colonization of fungal communities has become a research hotspot. Compared to normal tissue, the abundance of fungi in tumor tissues of PDA patients increased by up to 3000 times, with the enrichment of Malassezia being particularly significant. These fungi activate the host complement system (such as the MBL-C3 pathway), triggering local inflammatory responses and promoting tumor growth. This indicates that Malassezia is not only a “marker” in the tumor microenvironment but also a…

We report that METTL3, an oncogene regulates the expression of SMAD4, a tumor-suppressor via miR-146a-5p, thus unveiling a novel regulatory axis of METTL3/miR-146a-5p/SMAD4 in OSCC, which can potentially have therapeutic implications BUFFALO, NY – May 9, 2025 – A new research paper was published in Oncotarget, Volume 16, on May 8, 2025, titled “METTL3 promotes oral squamous cell carcinoma by regulating miR-146a-5p/SMAD4 axis.” In this study, researchers Jayasree Peroth Jayaprakash, Pragati Karemore, and Piyush Khandelia from the Birla Institute of Technology and Science, India,…